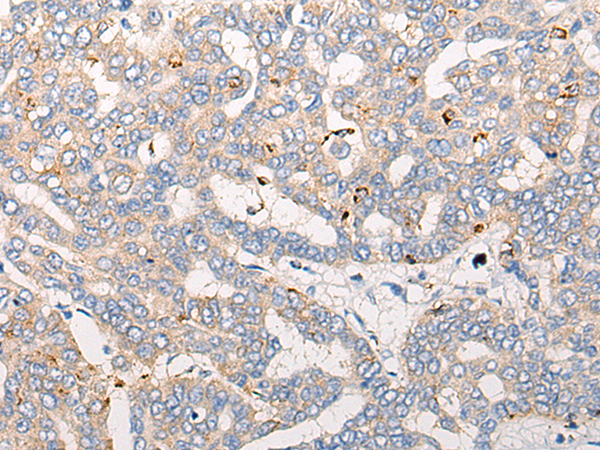

-
分类: 科研抗体货号: P09537别名: CLN80; p80-coilin应用: WB反应种属: Human
-
分类: 科研抗体货号: P09538别名: STL2; COLL6; CO11A1应用: IHC反应种属: Human, Mouse, Rat
-
分类: 科研抗体货号: P09556别名: TFP; RNF23; TRIM39B应用: WB,IHC反应种属: Human, Mouse, Rat
-
分类: 科研抗体货号: P09536别名: CDG2I; GTC90; GOLTC1应用: IHC反应种属: Human, Mouse
-
分类: 科研抗体货号: P09555别名: DMC1H; LIM15; dJ199H16.1应用: IHC反应种属: Human, Mouse
-
分类: 科研抗体货号: P09535别名: LDLC应用: IHC反应种属: Human, Mouse
-
分类: 科研抗体货号: P09554别名: TAZ应用: WB,IHC反应种属: Human, Mouse
-
分类: 科研抗体货号: P09531别名: NOT2; CDC36; NOT2H; HSPC131应用: IHC反应种属: Human, Mouse
-
分类: 科研抗体货号: P09553别名: ARA; PXE; MLP1; MRP6; PXE1; URG7; ABC34; GACI2; MOATE; MOAT-E; EST349056应用: IHC反应种属: Human, Mouse, Rat
-
分类: 科研抗体货号: P09529别名:应用: IHC反应种属: Human, Mouse

鄂公网安备42018502007531号
鄂公网安备42018502007531号

